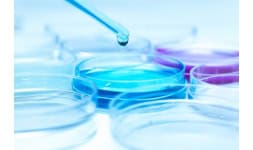

Ensayos para el control de la calidad de aire, suelo y agua. Se basa en la toma de muestras que permita conocer las concentraciones de contaminantes y de otras substancias que puedan ser parte del

Ensayos para el control de la calidad de aire, suelo y agua. Se basa en la toma de muestras que permita conocer las concentraciones de contaminantes y de otras substancias que puedan ser parte del

Se trata de ensayos que tienen como finalidad la determinación de cantidad y tipo de bacterias en una muestra.
Se trata de ensayos que tienen como finalidad la determinación de cantidad y tipo de bacterias en una muestra.

Ensayos químicos, biológicos, físicos o moléculares realizados a muestras biológicas con la finalidad de ayudar a los médicos con el diagnóstico, tratamiento o seguimiento de pacientes.
